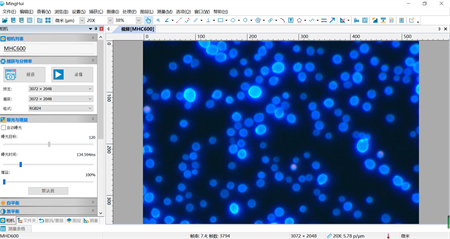

显微镜相机可以将显微镜中观察到的微小物体放大并通过软件进行图像处理和分析,实时显示在电脑或手机屏幕上,让用户轻松地拍摄高质量的显微镜图像。显微镜相机能够满足高级科研应用的各类需求,具有高清晰度、高亮度和高分辨率等优点,让人们更加清晰地观察微观世界。

显微镜相机应用领域:
1.生命科学:显微镜相机可以用于细胞、组织和器官的结构和功能观察、组织切片、病理学等方面。
2.材料科学:显微镜相机可以用于材料分析、表面形貌观察等方面。
3.教育科研:显微镜相机可以用于学校实验室、科研机构等场所。
针对不同的应用场景和需求,显微镜相机的参数也有所不同,常见的参数包括分辨率、帧率、像素大小等,可以通过显微镜摄像头定制,定制专属的光学参数和软件功能,获得更清晰、更准确的视野。
△显微镜USB2.0 CMOS相机

USB2.0与CMOS图像传感器相机(USB2.0 Advanced CMOS 相机);
采用USB2.0作为数据传输接口;
硬件分辨率横跨1.2M~8.3M等多种;
实时8/12位切换,任意ROI尺寸。
△显微镜USB3.0 CMOS相机

采用Sony Exmor CMOS背照式传感器的C接口CMOS USB3.0相机;
传感器采用双层降噪技术,具有超高的灵敏度以及超低噪声;
分辨率横跨40万~2000万,图像传输速度快,随相机提供高级视频与图像处理应用软件;
广泛用于显微图像的拍摄与记录。
△显微镜USB3.0 CCD相机

USB3.0接口CCD相机,其感光芯片采用索尼ExView HAD CCD芯片;
采用SONY EXview技术的C接口CCD相机,分辨率有1.4M~12M等多种;
IR-CU红外窗口,滤除红外,又起保护传感器的作用;
在黑暗的环境下也可得到高亮度的照片;
FPGA控制支持长达1分钟长曝光,保证捕获弱荧光图像;
可用于弱光或荧光图像的拍摄与分析。
△显微镜制冷相机

高效制冷模块,大大降低了图像噪声,保证了图像质量的获取。
双级专业设计的高性能TE冷却结构,散热速度快;
温度任意可控,最高达50度温度降幅,确保在视频或图像噪声小的情况下尽可能高的光电转换量子效率;
防结雾结构,确保传感器表面在低温情况下不会防结雾;
支持触发操作模式,软件触发或外部触发,支持一次触发采集单张或多张图片。
通过数码成像系统,可以直接在电脑上观察图像,还能将所成像在电脑上保存成图片,大大的方便了使用者将图像数据保存的要求,也更加方便了资料数据的管理和编辑。并且能通过专业的软件图像进行调整,标注,拼接,合成,测量等,形成图文文件,可互相传阅。
如需显微镜摄像头定制或者了解更多解决方案,请与我们联系!

热线020-87096762

致电13418179239

